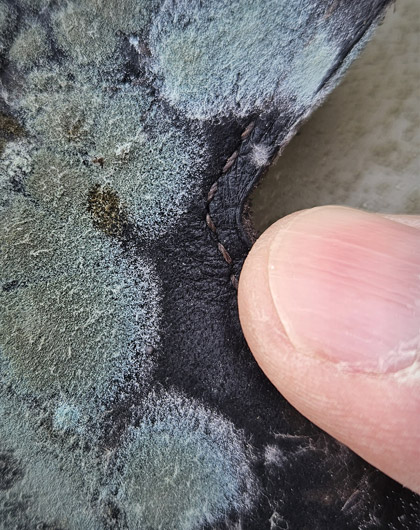
Mold on Clothes: How It Happens and What You Can Do About It

Mold on Clothes: How It Happens and What You Can Do About It
Most homeowners think of mold as a problem limited to basements, walls, or bathrooms, but clothing can be one of its most unexpected victims. Mold on clothes does not just leave stains or create odors - it may weaken fabrics, can spread spores throughout your home, and in some cases may affect indoor comfort. Understanding how and why mold grows on clothing is essential for effective prevention and removal, whether it starts in a damp washer, a humid closet, or a poorly ventilated storage area.
While we do not clean mold from clothing, FDP Mold Remediation specializes in identifying and addressing moisture problems and hidden mold sources within the building that often allow clothing to become moldy in the first place. This guide explains what mold on clothes looks like, why it forms, what homeowners can do to clean affected items, and when it may make sense to have your home inspected for a broader moisture or mold issue.